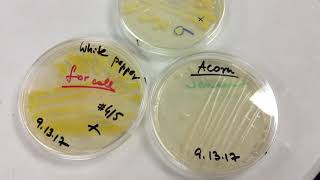

AP Biology Field Experiment video
Online izle ve mp4 mp3 formatlarinda yukle

Videonun muddeti: 9:58
AP Biology Field Experiment videosu mp4 ve mp3 yuklemek ucun hazirdir
Diqqet! Siz Mp4 yukle ve ya Mp3 yukle duymesine basdiqdan sonra eger sistem sizi reklam sehifesine atarsa o zaman derhal geri qayidib emeliyyati tekrar edin ve faylin yuklemek ucun hazir olmasini gozleyin
Videodan Mp4 Yukle
Videodan Mp3 Yukle-1
Videodan Mp3 Yukle-2
Oxshar Axtarishlar
 AP Biology Field Experiment
AP Biology Field Experiment AP Biology - Cornell Cooperative Extension Field Trip - 2017
AP Biology - Cornell Cooperative Extension Field Trip - 2017 Experimental Design AP Bio Exam Review with Mr W from Learn Biology com
Experimental Design AP Bio Exam Review with Mr W from Learn Biology com Experimental Design Review For AP Biology Students
Experimental Design Review For AP Biology Students AP Biology and AP Environmental Field Trip
AP Biology and AP Environmental Field Trip AP Biology Lab 5: Cellular Respiration
AP Biology Lab 5: Cellular Respiration 0.01 AP Bio Skills (experimental design and intro to graphing)
0.01 AP Bio Skills (experimental design and intro to graphing) AP Biology Field Experience
AP Biology Field Experience PHOTOSYNTHESIS LAB: Floating Leaf Disks: AP Biology
PHOTOSYNTHESIS LAB: Floating Leaf Disks: AP Biology
Video Mp4 Mp3Azwap.Biz
Azwap.Biz 2021-2023


 AP Biology Field Experiment
AP Biology Field Experiment AP Biology - Cornell Cooperative Extension Field Trip - 2017
AP Biology - Cornell Cooperative Extension Field Trip - 2017 Experimental Design AP Bio Exam Review with Mr W from Learn Biology com
Experimental Design AP Bio Exam Review with Mr W from Learn Biology com Experimental Design Review For AP Biology Students
Experimental Design Review For AP Biology Students AP Biology and AP Environmental Field Trip
AP Biology and AP Environmental Field Trip AP Biology Lab 5: Cellular Respiration
AP Biology Lab 5: Cellular Respiration 0.01 AP Bio Skills (experimental design and intro to graphing)
0.01 AP Bio Skills (experimental design and intro to graphing) AP Biology Field Experience
AP Biology Field Experience PHOTOSYNTHESIS LAB: Floating Leaf Disks: AP Biology
PHOTOSYNTHESIS LAB: Floating Leaf Disks: AP Biology